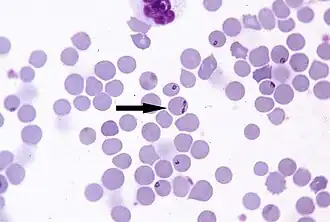
Description de l'image Babesia-divergens.jpg.

Babesia divergens
| Règne | Chromalveolata |
|---|---|
| Division | Alveolata |
| Embranchement | Apicomplexa |
| Classe | Aconoidasida |
| Sous-classe | Piroplasmasina |
| Ordre | Piroplasmida |
| Famille | Babesiidae |
| Genre | Babesia |
(M'Fadyean & Stockman, 1911)
Babesia divergens est une espèce d'eucaryotes unicellulaires de l'infra-règne des Alveolata. C'est un parasite intraerythrocytique transmis par la tique Ixodes ricinus. Il est l'un des agents principaux de la babésiose bovine en Europe, mais peut aussi toucher d'autres animaux[1]. Les jeunes bovins sont moins sensibles.
Contamination
Après morsure de l'hôte par la tique, Babesia divergens infeste les hématies en pénétrant la membrane. Elle va s'y multiplier. Les cycles de multiplication sont plus ou moins nombreux, et s'ils sont trop nombreux peuvent donner lieu à l'éclatement des hématies. La reproduction sexuée s'effectue chez la tique[2], qui est infestée par la morsure d'un animal contaminé.
Les signes cliniques observables s'expliquent en partie par l'éclatement des hématies[2].
Notes et références
- ↑ F. Beugnet et Y. Moreau, « Babesiosis », Revue Scientifique Et Technique (International Office of Epizootics), vol. 34, no 2, , p. 627–639 (ISSN 0253-1933, PMID 26601462, DOI 10.20506/rst.34.2.2385, lire en ligne)
- 1 2 (en) Carlos E. Suarez, Heba F. Alzan, Marta G. Silva et Vignesh Rathinasamy, « Unravelling the cellular and molecular pathogenesis of bovine babesiosis: is the sky the limit? », International Journal for Parasitology, vol. 49, no 2, , p. 183–197 (ISSN 1879-0135, PMID 30690089, PMCID 6988112, DOI 10.1016/j.ijpara.2018.11.002, lire en ligne)
Voir aussi
Articles connexes
Liens externes
- (en) NCBI : Babesia divergens (taxons inclus)
- Ressources relatives au vivant :
- Portail de la microbiologie
- Portail de la parasitologie